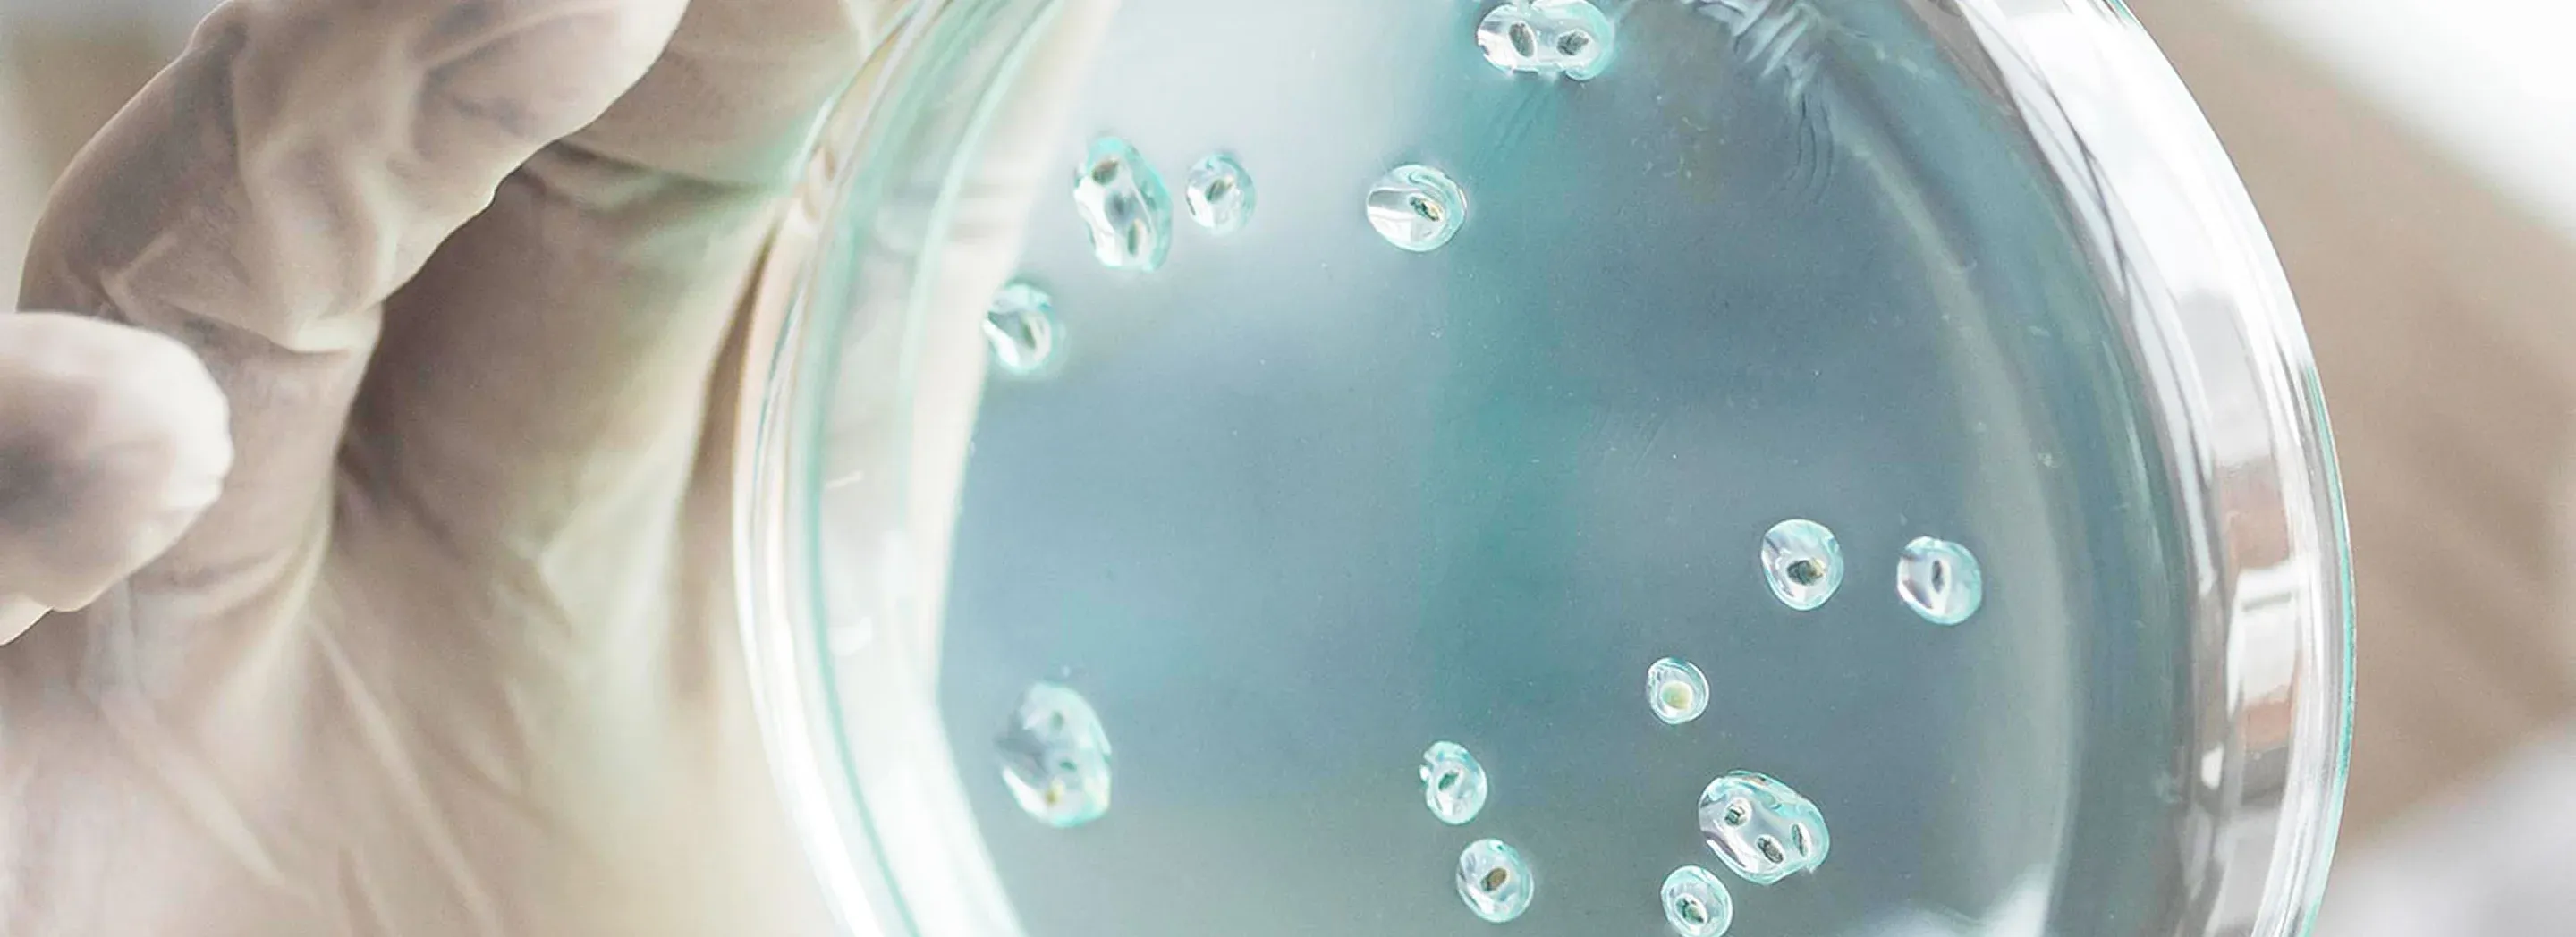
Szalka Petriego z hodowlą bakterii &ndash; badania nad skutecznością probiotyk&oacute;w YUN Probiotherapy

OCENA OSTATECZNEJ FORMUŁY
Podobnie jak prowadzimy wstępną selekcję składników, każda gotowa formulacja jest dokładnie testowana pod kątem zgodności z naszymi rygorystycznymi standardami.
Ostateczne formuły są wystawiane na działanie mikroorganizmów w warunkach odpowiadających rzeczywistemu użytkowaniu, aby ocenić wpływ produktu na rozwój tych drobnoustrojów.
Ponadto każdy produkt jest testowany pod kątem zgodności z naszymi szczepami Lactobacillus, dzięki czemu nawet kosmetyki nie zawierające probiotyków mogą być bezpiecznie łączone z pozostałymi produktami naszej marki.
W ten sposób możemy z pełnym przekonaniem gwarantować skuteczność działania bakterii probiotycznych!